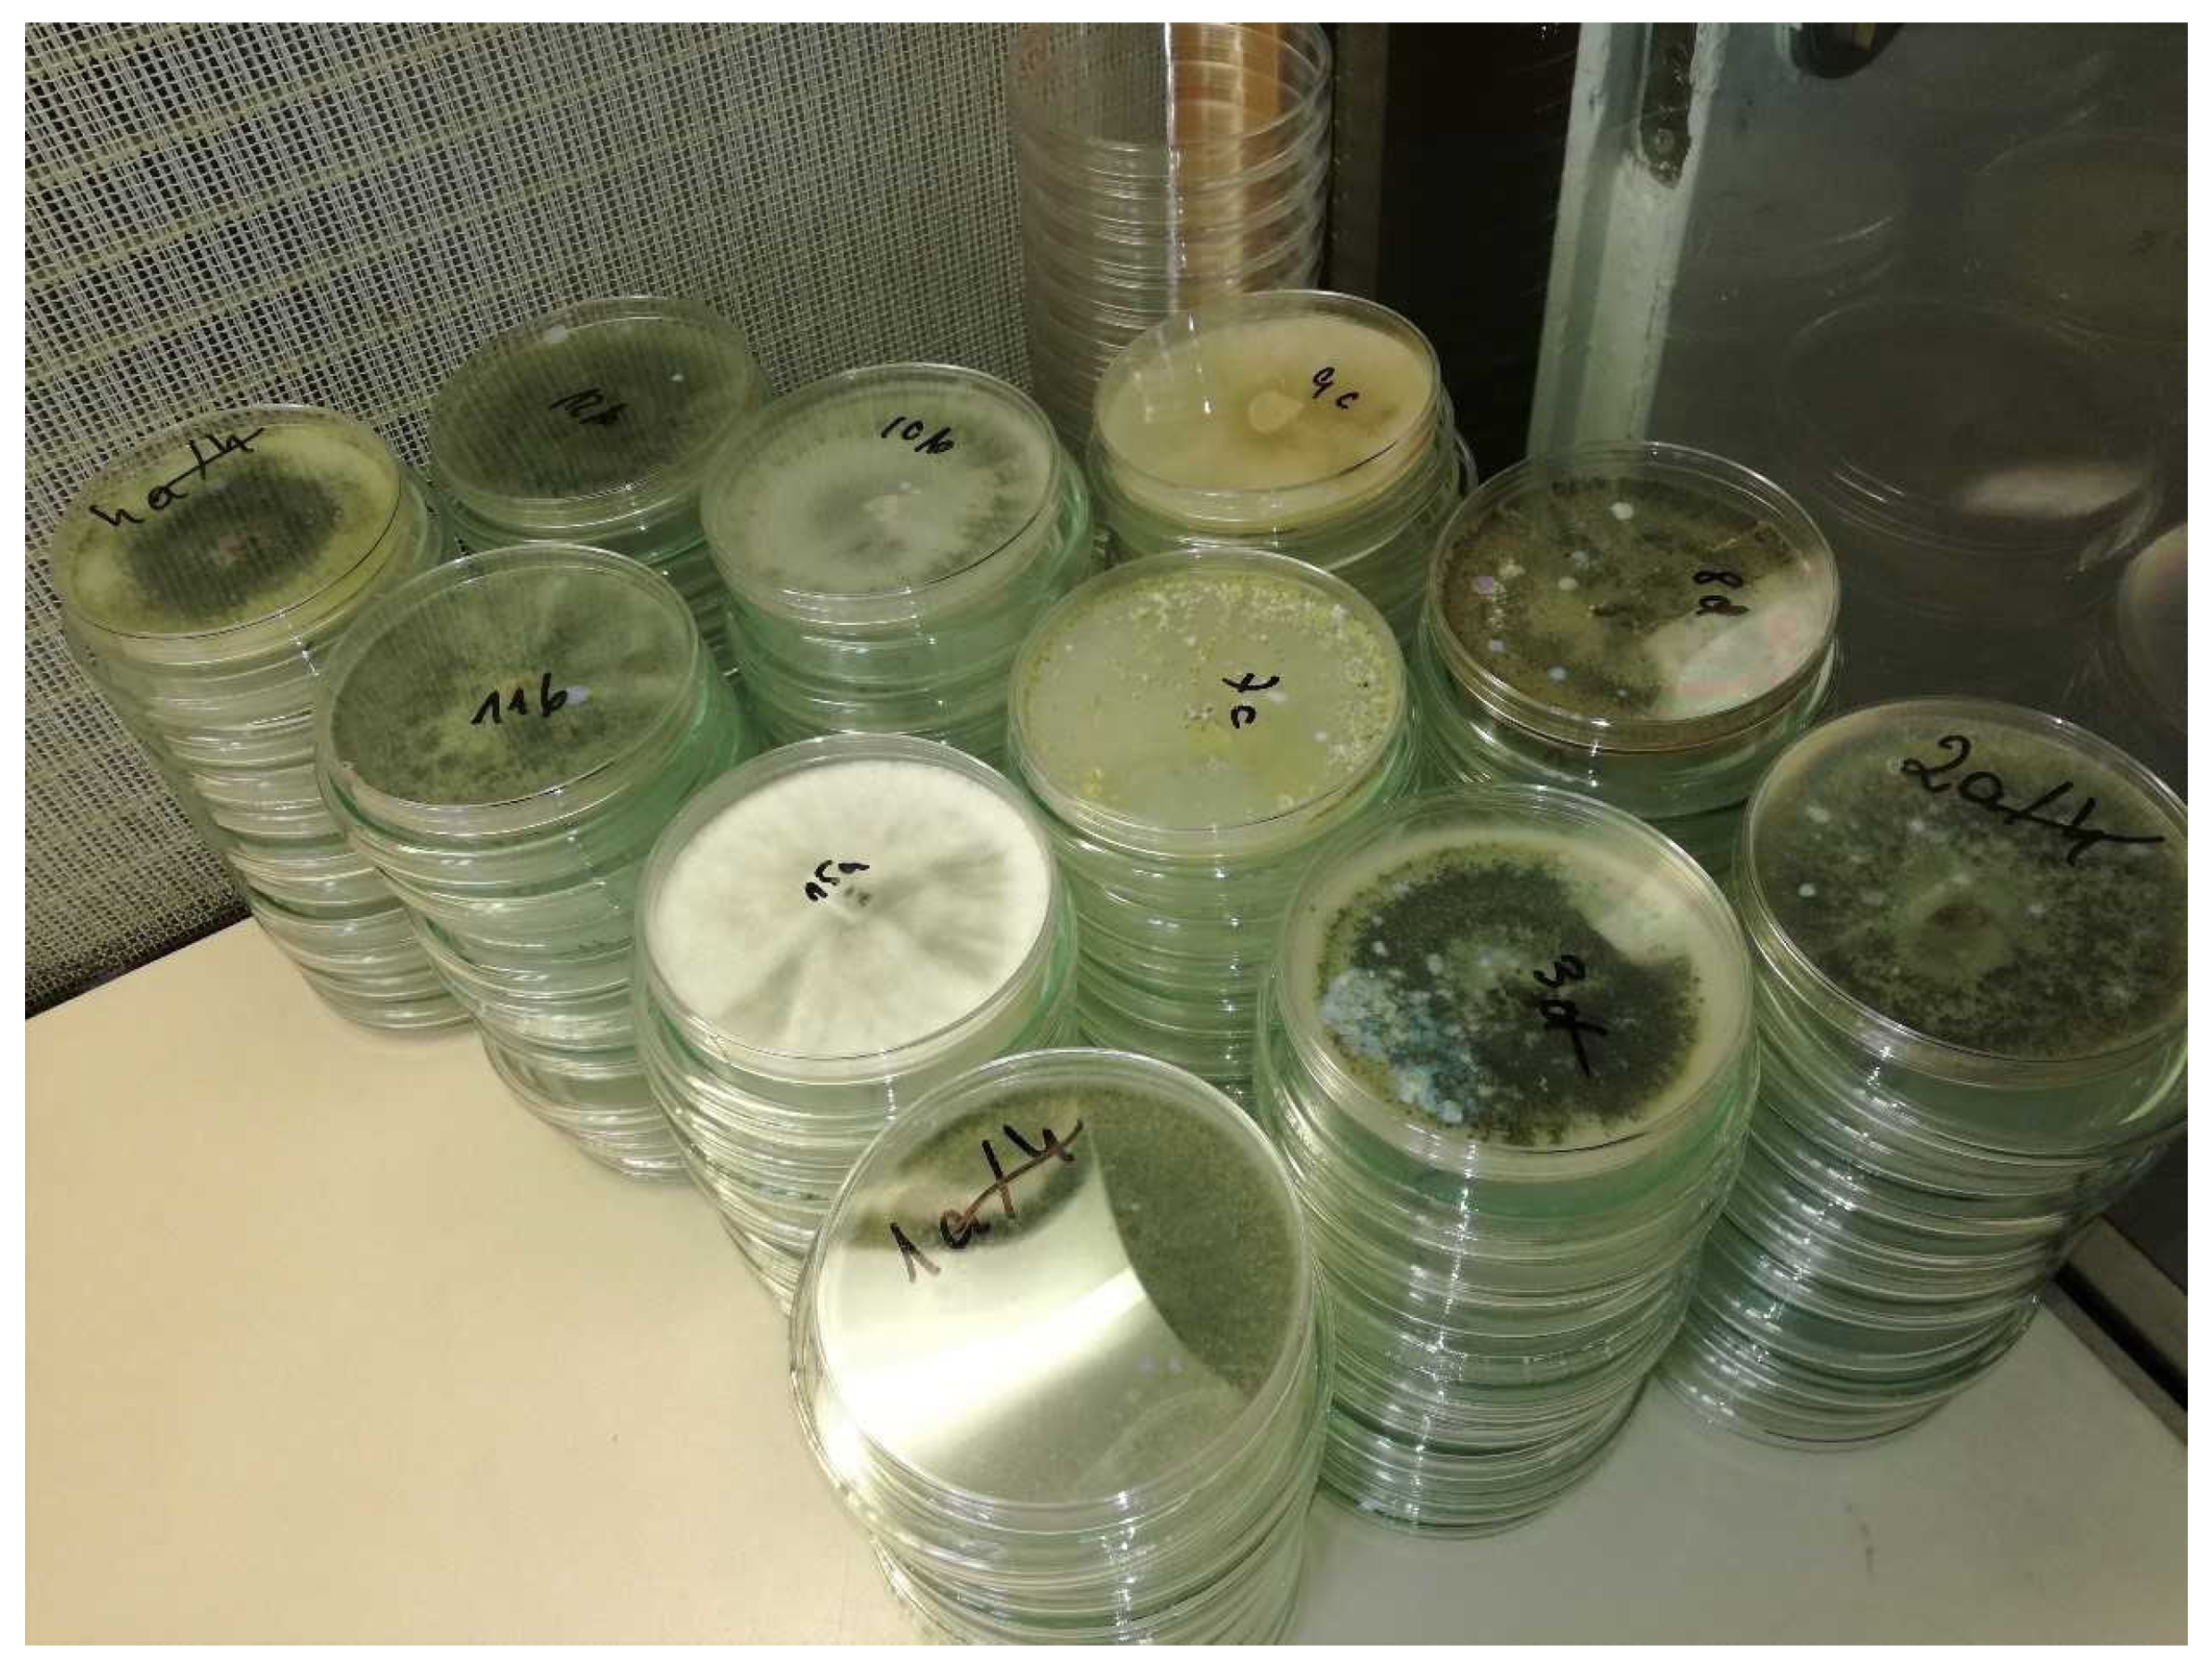
Ijms 23 15662 g002

Trichoderma spp. Improves Flowering, Quality, and Nutritional Status of Ornamental Plants
Abstract
1. Introduction
2. Classification and Morphology of Trichoderma spp.
3. The Impact of the Environment on the Population of Trichoderma spp.
4. Ways to Use Trichoderma spp.
5. Root Colonization by Fungi of the Trichoderma Genus
6. The Impact of Trichoderma spp. on the Quality of Ornamental Plants
Plant Height, Number of Shoots, and Leaves
7. Flowering of Plants Following the Application of Trichoderma spp.
7.1. Earliness of Flowering
7.2. The Quality of Flowers and Inflorescences
8. Chloroplast Pigment Content in Leaves Following the Application of Trichoderma spp.
9. Trichoderma spp. and Plant Nutrition
9.1. Macroelement Content in Leaves
9.2. Microelement Content in Leaves
10. Conclusions
Author Contributions
Funding
Institutional Review Board Statement
Informed Consent Statement
Data Availability Statement
Conflicts of Interest
References
- Du Jardin, P. Plant biostimulants: Definition, concept, main categories and regulation. Sci. Hortic. 2015, 196, 3–14. [Google Scholar] [CrossRef]
- Kisvarga, S.; Farkas, D.; Boronkay, G.; Neményi, A.; Orlóci, L. Effects of biostimulants in horticulture, with emphasis on ornamental plant production. Agronomy 2022, 12, 1043. [Google Scholar] [CrossRef]
- Wojtkowiak-Gebarowska, E. Mechanizmy zwalczania fitopatogenów glebowych przez grzyby z rodzaju Trichoderma. Postępy Mikrobiol 2006, 45, 261–273. [Google Scholar]
- Benìtez, T.; Rincòn, A.M.; Limòn, M.C.; Codòn, A.C. Biocontrol mechanisms of Trichoderma strains. Int. Microbiol. 2004, 7, 249–260. [Google Scholar]
- Świerczyńska, I.; Korbas, M.; Horoszkiewicz-Janka, J.; Danielewicz, J. Antagonistyczne oddziaływanie Trichoderma viride na patogeny z rodzaju Fusarium w obecności biopreparatów. J. Res. Appl. Agricult. Eng. 2011, 56, 157–160. [Google Scholar]
- Poveda, J. Trichoderma as biocontrol agent against pests: New uses for a mycoparasite. Biol. Control. 2021, 159, 104634. [Google Scholar] [CrossRef]
- Kosicka, D.; Wolna-Maruwka, A.; Trzeciak, M. Aspekty stosowania Trichoderma sp. w ochronie roślin i rozkładzie materii organicznej. Kosmos 2014, 63, 635–642. [Google Scholar]
- Vey, A.; Hoagland, R.E.; Butt, T.M. Toxic metabolites of fungal biocontrol agents. In Fungi as Biocontrol Agents: Progress, Problems and Potential; Butt, T.M., Jackson, C., Magan, N., Eds.; CABI Publishing: Wallingford, UK, 2001; pp. 311–346. [Google Scholar]
- Howell, C.R. Understanding the mechanisms employed by Trichoderma virens to effect biological control of cotton diseases. Phytopathology 2006, 96, 178–180. [Google Scholar] [CrossRef]
- Reino, J.L.; Guerrero, R.F.; Hernández-Galán, R.; Collado, I.G. Secondary metabolites from species of the biocontrol agent Trichoderma. Phytochem. Rev. 2008, 7, 89–123. [Google Scholar]
- Stewart, A.; Hill, R. Applications of Trichoderma in plant growth promotion. In Biotechnology and Biology of Trichoderma; Gupta, V.K., Schmoll, M., Herrera-Estrella, A., Upadhyay, R.S., Druzhinina, I., Tuohy, M.G., Eds.; Elsevier: Amsterdam, The Netherlands, 2014; pp. 415–428. [Google Scholar]
- Nieto-Jacobo, M.F.; Steyaert, J.M.; Salazar-Badillo, F.B.; Nguyen, D.V.; Rostás, M.; Braithwaite, M.; de Souza, J.T.; Jimenez-Bremont, J.F.; Ohkura, M.; Stewart, A.; et al. Environmental growth conditions of Trichoderma spp. affects indole acetic acid derivatives, volatile organic compounds, and plant growth promotion. Front. Plant Sci. 2017, 8, 102. [Google Scholar] [CrossRef] [PubMed]
- Contreras-Cornejo, H.A.; Macías-Rodríguez, L.; Cortés-Penagos, C.; López-Bucio, J. Trichoderma virens, a plant beneficial fungus, enhances biomass production and promotes lateral root growth through an auxin-dependent mechanism in Arabidopsis. Plant Physiol. 2009, 149, 1579–1592. [Google Scholar] [CrossRef] [PubMed]
- Yedidia, I.; Srivastava, A.K.; Kupalnik, Y.; Chet, I. Effect of Trichoderma harzianum on microelement concentrations and increased growth of Cucumber plants. Plant Soil 2001, 235, 235–242. [Google Scholar] [CrossRef]
- Harman, G.E.; Howell, C.R.; Viterbo, A.; Chet, I.; Lorito, M. Trichoderma species–opportunistic, avirulent plant symbionts. Nature Rev. Microbiol. 2004, 2, 43–56. [Google Scholar] [CrossRef] [PubMed]
- Lorito, M.; Woo, S.; Harman, G.; Monte, E. Translational research on Trichoderma: From ‘omics to the field. Ann. Rev. Phytopathol. 2010, 48, 395–417. [Google Scholar] [CrossRef]
- Megersa, H.G.; Lemma, D.T.; Banjawu, D.T. Effects of plant growth retardants and pot sizes on the height of potting ornamental plants: A short review. J. Hortic. 2018, 5, 1. [Google Scholar] [CrossRef]
- Sriprapat, W.; Thiravetyan, P. Efficacy of ornamental plants for benzene removal from contaminated air and water: Effect of plant associated bacteria. Int. Biodeterior. Biodegrad. 2016, 113, 262–268. [Google Scholar] [CrossRef]
- Lekawatana, S.; Suwannamek, B. Ornamental plants in Thailand. Acta Hortic. 2017, 1167, 11–16. [Google Scholar] [CrossRef]
- Junqueira, A.H.; Peetz, M. Brazilian consumption of flowers and ornamental plants: Habits, practices and trends. Ornam. Hortic. 2017, 23, 178. [Google Scholar] [CrossRef]
- Briercliffe, T. Growing the global market for ornamentals. Acta Hortic. 2017, 1165, 1–8. [Google Scholar] [CrossRef]
- Simkin, A.J.; Gaffe, J.; Alcaraz, J.P.; Carde, J.P.; Bramley, P.M.; Fraser, P.D.; Kuntz, M. Fibrillin influence on plastid ultrastructure and pigment content in tomato fruit. Phytochemistry 2007, 68, 1545–1556. [Google Scholar] [CrossRef]
- Langi, P.; Kiokias, S.; Varzakas, T.; Proestos, C. Carotenoids: From plants to food and feed industries. Methods Mol. Biol. 2018, 1852, 57–71. [Google Scholar] [CrossRef]
- Meléndez-Martínez, A.J.; Mandić, A.I.; Bantis, F.; Böhm, V.; Borge, G.I.A.; Brnĉić, M.; Bysted, A.; Cano, M.P.; Dias, M.G.; Elgersma, A.; et al. A comprehensive review on carotenoids in foods and feeds: Status quo, applications, patents, and research needs. Crit. Rev. Food Sci. Nutr. 2022, 62, 1999–2049. [Google Scholar] [CrossRef]
- Samuels, G. Trichoderma: A review of biology and systematic of the genus. Mycol. Res. 1996, 100, 923–935. [Google Scholar] [CrossRef]
- Index Fungorum. Available online: http://www.indexfungorum.org/names/NamesRecord.asp?RecordID=10282 (accessed on 2 November 2022).
- Tulasne, L.; Tulasne, R. De quelques Sphéries fungicoles, à propos d’un mémoire de M. Antoine de Bary sur les Nyctalis. Ann. Sci. Nat. Bot. 1860, 13, 5–19. [Google Scholar]
- Bisby, G.R. Trichoderma viride Pers. ex Fries and notes on Hypocrea. Trans. Br. Mycol. Soc. 1939, 23, 149–168. [Google Scholar] [CrossRef]
- Bissett, J. A revision of the genus Trichoderma. II. Infrageneric classification. Can. J. Bot. 1991, 69, 2357–2372. [Google Scholar] [CrossRef]
- Bissett, J. A revision of the genus Trichoderma. III. Sect. Pachybasium. Can. J. Bot 1991, 69, 2373–2417. [Google Scholar] [CrossRef]
- Bissett, J. A revision of the genus Trichoderma. IV. Additional notes on section Longibrachiatum. Can. J. Bot. 1991, 69, 418–2420. [Google Scholar] [CrossRef]
- Kullnig-Gradinger, C.M.; Szakacs, G.; Kubicek, C.P. Phylogeny and evolution of the fungal genus Trichoderma: A multigene approach. Mycol. Res. 2002, 106, 757–767. [Google Scholar] [CrossRef]
- Kindermann, J.; El-Ayouti, Y.; Samuels, G.J.; Kubicek, C.P. Phylogeny of the genus Trichoderma based on sequence analysis of the internal transcribed spacer region 1 of the rDNA clade. Fungal Genet. Biol. 1998, 24, 298–309. [Google Scholar] [CrossRef]
- Druzhinina, I.; Kubicek, C.P. Species concepts and biodiversity in Trichoderma and Hypocrea: From aggregate species to species clusters? J. Zhejiang Univ. Sci. 2005, 6, 100–112. [Google Scholar] [CrossRef] [PubMed]
- Blaszczyk, L.; Siwulski, M.; Sobieralski, K.; Lisiecka, J.; Jędryczka, M. Trichoderma spp.–application and prospects for use in organic farming and industry. J. Plant Prot. Res. 2014, 54, 309–317. [Google Scholar] [CrossRef]
- Kredics, L.; Antal, Z.; Mancziger, L.; Szekeres, A.; Kevei, F.; Nagy, E. Influence of environmental parameters on Trichoderma strains with biocontrol potential. Food Technol. Biotechnol. 2003, 4, 37–42. [Google Scholar]
- Rafai, M.A. A revision of the genus Trichoderma. Mycolog. Papers 1969, 116, 1–56. [Google Scholar]
- Papavizas, G.C. Trichoderma and Gliocliadum: Biology, ecology, and potential for biocontrol. Ann. Rev. Phytopathol. 1985, 23, 23–54. [Google Scholar] [CrossRef]
- Strzelczyk, E. Biologiczne zwalczanie roślinnych patogenów glebowych. Postęp Mikrobiol 1988, 23, 255–272. [Google Scholar]
- Tanaka, S.; Funakawa, S.; Kaewkhongkha, T.; Yonebayashi, K. Labile pools of organic matter and microbial biomass in the surface soil under shifting cultivation in northen Thailand. Soil Sci Plant Nutr. 1998, 44, 527–537. [Google Scholar] [CrossRef]
- Das, M.; Banerjee, R.; Bal, S. Multivariable parameter optimization for the endoglucanase production by Trichoderma reesei Rut C30 from Ocimum gratissimum seed. Braz. Arch. Biol. Technol. 2008, 51, 35–41. [Google Scholar] [CrossRef]
- Jaworska, M.; Dłużniewska, J. Wpływ jonów miedzi na wzrost i aktywność biologiczną wybranych gatunków Trichoderma. Chem. Inż. Ekolog. 1999, 6, 601–605. [Google Scholar]
- Lanzuise, S.; Ruocco, M.; Scala, V.; Woo, S.L.; Scala, F.; Vinale, F.; del Sorbo, G.; Lorito, M. Cloning of ABC transporter-encoding genes in Trichoderma spp., to determine their involvement in biocontrol. J. Plant Pathol. 2002, 84, 184. [Google Scholar]
- Jones, P.M.; George, A.M. The ABC transporter structure and mechanism: Perspectives on recent research. Cell. Mol. Life Sci. 2004, 61, 682–699. [Google Scholar] [CrossRef] [PubMed]
- Woo, S.L.; Ruocco, M.; Vinale, F.; Nigro, M.; Marra, R.; Lombardi, N.; Pascale, A.; Lanzuise, S.; Manganiello, G.; Lorito, M. Trichoderma-based products and their widespread use in agriculture. Open Mycol. J. 2014, 8, 71–126. [Google Scholar] [CrossRef]
- Biopartner. Available online: https://biopartner.com.pl/produkt/asperello-t-34/ (accessed on 7 November 2022).
- Middeldatabasen. Available online: https://middeldatabasen.dk/product.asp?productID=70131 (accessed on 7 November 2022).
- Agrauxine by Lesaffre. Available online: https://agrauxine.com/fr/produit/esquive-wp/ (accessed on 7 November 2022).
- Blomster Landet. Available online: https://www.blomsterlandet.se/produkter/tillbehor/vaxtskydd/biologisk-bekampning/binab-t-nyttosvamp-39768/ (accessed on 7 November 2022).
- LambrouAgroLtd. Available online: https://www.lambrouagro.com.cy/?pageid=ES&sub_action=details&sa=p&pid=50455&l_act=chnglng&lng=6 (accessed on 7 November 2022).
- Abricoorganics. Available online: https://www.arbico-organics.com/product/rootshield-wp-trichoderma-harzianum-strain-T22-fungicide/natural-organic-plant-disease-control (accessed on 7 November 2022).
- Andermat. Available online: https://www.andermattuk.com/t-gro (accessed on 7 November 2022).
- Koppert. Available online: https://www.koppert.co.uk/content/uk/Documents/General_Terms_and_Conditions/Trianum-P_UK_label_050520.pdf (accessed on 7 November 2022).
- Agrimm. Available online: http://agrimm.co.nz/trichopel/ (accessed on 7 November 2022).
- Certis. Available online: https://www.certiseurope.com/news-media/news/articles/news/biological-soil-fungicide-tusal (accessed on 7 November 2022).
- Andrzejak, R.; Janowska, B. Flowering, nutritional status, and content of chloroplast pigments in leaves of Gladiolus hybridus L. ‘Advances Red’ after application of Trichoderma spp. Sustainability 2022, 14, 4576. [Google Scholar] [CrossRef]
- Janowska, B.; Andrzejak, R.; Kosiada, T. The influence of fungi of the Trichoderma genus on the flowering of Freesia refracta Klatt ‘Argentea’ in winter. Hort. Sci. 2020, 47, 203–210. [Google Scholar] [CrossRef]
- Andrzejak, R.; Janowska, B.; Reńska, B.; Kosiada, T. Effect of Trichoderma spp. and fertilization on the flowering of Begonia × tuberhybrida Voss. ‘Picotee Sunburst’. Agronomy 2021, 11, 1278. [Google Scholar] [CrossRef]
- Prisa, D.; Sarrocco, S.; Forti, M.; Burchi, G.; Vannacci, G. Endophytic ability of Trichoderma spp. as inoculants for ornamental plants innovative substrates. J. Plant Pathol. 2013, 86, 169–174. [Google Scholar]
- Blaszczyk, L.; Witaszak, N.; Basinska-Barczak, A.; Marczak, L.; Sawikowska, A.; Perlikowski, D.; Kosmala, A. Reakcja roślin pszenicy zwyczajnej (Triticum aestivum L.) na kolonizację korzeni przez grzyby Trichoderma. Biul. Inst. Hod. Aklim. Roślin 2019, 285, 129–130. [Google Scholar]
- Souza, R.; Ambrosini, A.; Passaglia, L.M. Plant growth-promoting bacteria as inoculants in agricultural soils. Genet. Mol. Biol. 2015, 38, 401–419. [Google Scholar] [CrossRef]
- Berg, G. Plant-microbe interactions promoting plant growth and health: Perspectives for controlled use of microorganisms in agriculture. Appl. Microbiol. Biotechnol. 2009, 84, 11–18. [Google Scholar] [CrossRef]
- Druzhinina, I.S.; Seidl-Seiboth, V.; Herrera-Estrella, A.; Horwitz, B.A.; Kenerley, C.M.; Monte, E.; Mukherjee, P.; Zeilinger, S.; Grigoriew, I.V.; Kubicek, C.P. Trichoderma: The genomics of opportunistic success. Nat. Rev. Microbiol. 2011, 16, 749–759. [Google Scholar] [CrossRef]
- Vargas, W.A.; Crutcher, F.K.; Kenerley, C.M. Functional characterization of a plant-like sucrose transporter from the beneficial Fungus Trichoderma virens. Regulation of the symbiotic association with plants by sucrose metabolism inside the fungal cells. New Phytol. 2011, 189, 777–789. [Google Scholar] [CrossRef] [PubMed]
- Hermosa, R.; Viterbo, A.; Chet, I.; Monte, E. Plant-beneficial effects of Trichoderma and of its genes. Microbiol. 2012, 158, 17–25. [Google Scholar] [CrossRef] [PubMed]
- Stepanova, A.N.; Yun, J.; Likhacheva, A.V.; Alonso, J.M. Multilevel interactions between ethylene and auxin in Arabidopsis roots. Plant Cell. 2007, 19, 2169–2185. [Google Scholar] [CrossRef] [PubMed]
- Hou, X.; Lee, L.Y.; Xia, K.; Yan, Y.; Yu, H. DELLAs modulate jasmonate signaling via competitive binding to JAZs. Dev. Cell 2010, 19, 884–894. [Google Scholar] [CrossRef] [PubMed]
- Kazan, K.; Manners, J.M. Represory JAZ i orkiestracja przesłuchów fitohormonów. Trendy Plant Sci. 2012, 17, 22–31. [Google Scholar] [CrossRef]
- Brotman, Y.; Landau, U.; Cuadros-Inostroza, Á.; Takayuki, T.; Fernie, A.R.; Viterbo, A.; Willmitzer, L. Correction: Trichoderma-plant root colonization: Escaping early plant defense responses and activation of the antioxidant machinery for saline stress tolerance. PLoS Pathog. 2013, 9, e10.1371. [Google Scholar] [CrossRef]
- Cig, A.; Aydin, M.H. The effects of Trichoderma species on some parameters of the tulip (Tulipa gesneriana cv. “Golden Parade”). Fresen. Environ. Bull. 2019, 28, 1522–1530. [Google Scholar]
- Yahya, A.B.; Al-Sawaf, M.D.; Al-Morad, N.Y. Effect of biofertilizer Trichoderma harzianum t-22 application, growing medium and training methods on some characteristics for Lantana camara plants. Mesopotamia J. Agric. 2021, 49, 95–103. [Google Scholar] [CrossRef]
- Prisa, D. Trichoderma viride inoculated in the growing medium for the vitamin C increase in the leaves of Kalanchoe spp. and defense against Pithyum sp. Adv. Res. Rev. 2020, 5, 89–96. [Google Scholar] [CrossRef]
- Prisa, D. Trichoderma harzianum: Biocontrol to Rhizoctonia solani and biostimulation in Pachyphytum oviferum and Crassula falcata. World J. Adv. Res. Rev. 2019, 3, 11–18. [Google Scholar] [CrossRef]
- Sisodia, A.; Pal, A.; Singh, A.K. Varietal response and effect of Trichoderma on flowering in gladiolus. J. Pharmacogn. Phytochem. 2018, 7, 3658–3660. [Google Scholar]
- Da Cruz, L.; Ludwig, F.; Steffen, G.; Joseila Maldaner, J. Development and quality of gladiolus stems with the use of vermicompost and Trichoderma sp. in substrate. Ornam. Hortic. 2018, 24, 70–77. [Google Scholar] [CrossRef]
- Baker, N.R. Chlorophyll fluorescence: A probe of photosynthesis in vivo. Annu. Rev. Plant Biol. 2008, 59, 89–113. [Google Scholar] [CrossRef] [PubMed]
- Croft, H.; Chen, J.M.; Luo, X.; Bartlett, P.; Chen, B.; Staebler, R.M. Leaf chlorophyll content as a proxy for leaf photosynthetic capacity. Global Change Biol. 2017, 23, 3513–3524. [Google Scholar] [CrossRef]
- Harman, G.E.; Doni, F.; Khadka, R.B.; Uphoff, N. Endophytic strains of Trichoderma increase plants’ photosynthetic capability. J. Appl. Microbiol. 2021, 130, 529–546. [Google Scholar] [CrossRef]
- Andersson, S.C. Carotenoids, tocochromanols and chlorophylls in Sea buckthorn berries (Hippophae rhamnoides) and Rose hips (Rosa sp.). Doctoral Thesis, Swedish University of Agricultural Sciences, Alnarp, Sweden, 2009; pp. 15–20. [Google Scholar]
- Simkin, A.J. Carotenoids and apocarotenoids in planta: Their role in plant development, contribution to the flavour and aroma of fruits and flowers, and their nutraceutical benefits. Plants 2021, 10, 2321. [Google Scholar] [CrossRef]
- Widomska, J.; Kostecka-Gugała, A.; Latowski, D.; Gruszecki, W.I.; Strzałka, K. Calorimetric studies of the effect of cis-carotenoids on the thermotropic phase behavior of phosphatidylcholine bilayers. Biophys. Chem. 2008, 140, 108–114. [Google Scholar] [CrossRef]
- Altomare, C.; Norvell, W.A.; Biorkman, T.; Harman, G.E. Solubilization of phosphates and micronutrients by the plant-growth-promoting and biocontrol fungus Trichoderma harzianum Rifai 1295-2. Appl. Environ. Microbiol. 1999, 65, 2926–2933. [Google Scholar] [CrossRef]
- Metwally, R.A.; Al-Amri, S.M. Individual and interactive role of Trichoderma viride and arbuscular mycorrhizal fungi on growth and pigment content of onion plants. Let. Appl. Microbiol. 2020, 70, 79–86. [Google Scholar] [CrossRef]
- Gilliham, M.; Dayod, M.; Hocking, B.; Xu, B.; Conn, S.; Kaiser, B.; Leigh, R.; Tyerman, S. Calcium delivery and storage in plant leaves: Exploring the link with water flow. J. Exp. Bot. 2011, 62, 2233–2250. [Google Scholar] [CrossRef]
- Medaj, A.; Piechura, K.; Skrobot, K.; Sokulski, S. Determination of assimilable calcium for plants in the soil of the Kluczwoda Valley by atomic absorption spectrometry. Analit 2017, 3, 50–55. [Google Scholar]
- Metwally, R.A. Arbuscular mycorrhizal fungi and Trichoderma viride cooperative effect on biochemical, mineral content, and protein pattern of onion plants. J. Basic Microbiol. 2020, 60, 712–721. [Google Scholar] [CrossRef] [PubMed]
- Hosseinzeynali, A.; Abbaszadeh Dahaji, P.; Alaei, H.; Hosseinifard, J.; Akhgar, A. Effect of Trichoderma on growth and nutrition of pistachio trees under common garden condition. J. Soil Biol. 2021, 8, 115–129. [Google Scholar] [CrossRef]
- Khosa, S.S.; Younis, A.; Rayit, A.; Yasmeen, S.; Riaz, A. Effect of foliar application of macro and micro nutrients on growth and flowering of Gerbera jamesonii L. Am.-Euasian. J. Agric. Environ. Sci. 2011, 11, 736–757. [Google Scholar]
- Lahijie, M.F. Application of micronutrients FeSO4 and ZnSO4 on the growth and development of Gladiolus variety ‘Oscar’. Int. J. Agric. Crop Sci. 2012, 4, 718–720. [Google Scholar]

| Product Name | Species of Fungus of the Trichoderma Genus | References |
|---|---|---|
| Asperello T34 | T. asperellum | [46] |
| Binab TF WP | T. harzianum T. polysporum | [47] |
| Esquive WP | T. atroviride | [48] |
| BINAB T | T. polysporum T. harzianum | [49] |
| Remedier WP | T. asperellum T. gamsii | [50] |
| RootShield®-WP | T. harzianum | [51] |
| T-Gro | T. asperellum | [52] |
| Trianum-P | T. harzianum | [53] |
| Trichopel | T. harzianum | [54] |
| Tusal | T. harzianum T. viride | [55] |
| Species | Modifications | References |
|---|---|---|
| Begonia × tuberhybrida ‘Picotee Sunburst’ | Earlier flowering; more leaves; more buds and flowers; larger flowers; more chlorophyll; more Zn, Fe, B. | Andrzejak et al. [58] |
| Crassula falcata | More flowers. | Prisa [73] |
| Freesia reflacta ‘Argentea’ | Earlier flowering; more side flowering shoots; more flowers; more P, K, Ca, Fe, Mn, Zn, Cu. | Janowska et al. [57] |
| Gladiolus hybridus ‘Advances Red’ | Earlier blooming; longer flowering shoots; longer inflorescences; more flowers; more chlorophyll and carotenoids in leaves; more P, K, Ca, Zn, Fe, B. | Andrzejak and Janowska [56] |
| Gladiolus ‘Yellow Jester’, ‘Tiger Flame’, ‘Punjab Morning’, ‘Punjab Dawn’, ‘Pusa Kiran’, ‘Shubhangini’, ‘IIHR’, and ‘Dhanvantri’ | Longer flowering, longer inflorescences. | Sisodia et al. [74] |
| Gladiolus ‘Peter’s Pear’ | No effect on the quality of flowers and inflorescences. | da Cruz et al. [75] |
| Kalanchoe sp. | Longer and thicker shoots, more leaves. | Prisa [72] |
| Lantana camara | Longer and thicker shoots, more leaves. | Yahya et al. [71] |
| Pachyphodium oviferum | More flowers. | Prisa [73] |
| Tulipa gesneriana ‘Golden Parade’ | Earlier flowering, longer leaf blade. | Cig and Aydin [70] |
Publisher’s Note: MDPI stays neutral with regard to jurisdictional claims in published maps and institutional affiliations. |
© 2022 by the authors. Licensee MDPI, Basel, Switzerland. This article is an open access article distributed under the terms and conditions of the Creative Commons Attribution (CC BY) license (https://creativecommons.org/licenses/by/4.0/).
Share and Cite
Andrzejak, R.; Janowska, B. Trichoderma spp. Improves Flowering, Quality, and Nutritional Status of Ornamental Plants. Int. J. Mol. Sci. 2022, 23, 15662. https://doi.org/10.3390/ijms232415662
Andrzejak R, Janowska B. Trichoderma spp. Improves Flowering, Quality, and Nutritional Status of Ornamental Plants. International Journal of Molecular Sciences. 2022; 23(24):15662. https://doi.org/10.3390/ijms232415662
Chicago/Turabian StyleAndrzejak, Roman, and Beata Janowska. 2022. "Trichoderma spp. Improves Flowering, Quality, and Nutritional Status of Ornamental Plants" International Journal of Molecular Sciences 23, no. 24: 15662. https://doi.org/10.3390/ijms232415662
APA StyleAndrzejak, R., & Janowska, B. (2022). Trichoderma spp. Improves Flowering, Quality, and Nutritional Status of Ornamental Plants. International Journal of Molecular Sciences, 23(24), 15662. https://doi.org/10.3390/ijms232415662

